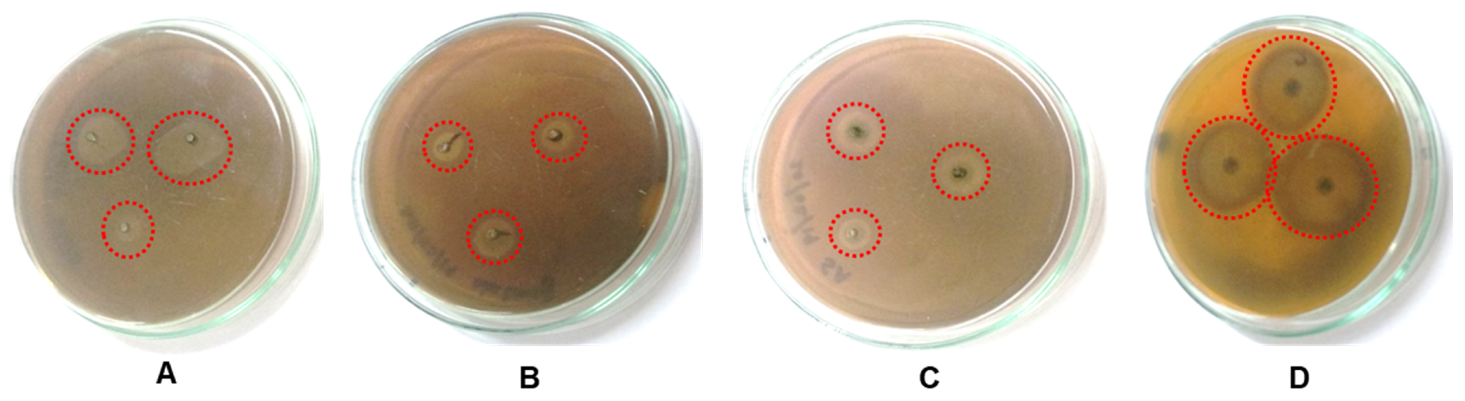
Processes 09 01341 g009

Phytosynthesis of Copper Nanoparticles Using Extracts of Spices and Their Antibacterial Properties
Abstract
1. Introduction
2. Materials and Methods
2.1. Biosynthesis of Copper Nanoparticles
2.2. Analytical Characterization of Biogenic CuNPs
2.3. Antibacterial Activity of Biogenic Copper Nanoparticles
2.4. Antibacterial Activity of Spice Extract
2.5. Extract Preparation and Chromatography
2.6. TLC-Direct Bioautography
3. Results and Discussion
3.1. Nanoparticle Synthesis
3.2. SEM Analysis
3.3. EDAX Analysis
3.4. Fourier-Transform Infrared (FTIR) and Gas Chromatography–Mass Spectrometry (GC–MS) Analysis
3.4.1. FTIR Characterization of CuNPs
3.4.2. GC–MS Analysis
3.5. Antibacterial Activity of Spice Extract by Disc Diffusion Method
3.6. Antibacterial Activity of CuNPs by Well-Diffusion Method
3.7. Thin-Layer Chromatography
3.8. TLC–Direct Bioautography
4. Conclusions
Author Contributions
Funding
Institutional Review Board Statement
Informed Consent Statement
Data Availability Statement
Conflicts of Interest
Abbreviations
| CuNPs | Copper nanoparticles |
| CuO | Copper oxide |
| NPs | Nanoparticles |
| SEM | Scanning electron microscopy |
| EDAX | Energy-dispersive X-ray analysis |
| FTIR | Fourier-transform infrared spectroscopy |
| GC-MS | Gas chromatography–mass spectrometry |
| TLC | Thin-layer chromatography |
| ZOI | Zone of inhibition |
| DMSO | Dimethyl sulfoxide |
| UV-vis | Ultraviolet-visible |
| ROS | Reactive oxygen species |
| RT | Retention time |
| NIST | National Institute of Standards and Technology |
| SE | Secondary electron |
| BSE | Backscattered electron |
| S. aureus | Staphylococcus aureus |
References
- Rai, M.; Acharya, D.; Wadegaonkar, P. Plant-Derived Antimycotic. In Current Trends and Future Prospects; Hartworth Press: New York, NY, USA, 2003; pp. 165–195. [Google Scholar]
- Dash, B.K.; Sultana, S.; Sultana, N. Antibacterial activities of methanol and acetone extracts of fenugreek (Trigonella foenum) and coriander (Coriandrum sativum). Life Sci. Med. Res. 2011, 27, 1–8. [Google Scholar]
- Balashanmugam, P.; Prabhu, D.; Devasena, T.; Hak, J.S.; Kim, K.W.; Jung, Y.S.; Song, H.J.; Kim, H.J.; Kumaran, R.S. Facile synthesis of silver nanoparticles using Asian spider flower and its in vitro cytotoxic activity against human breast carcinoma cells. Processes 2020, 8, 430. [Google Scholar]
- Shah, M.; Fawcett, D.; Sharma, S.; Tripathy, S.; Poinern, G. Green synthesis of metallic nanoparticles via biological entities. Materials 2015, 8, 7278–7308. [Google Scholar] [CrossRef]
- Chung, I.M.; Rahuman, A.A.; Marimuthu, S.; Kirthi, A.V.; Anbarasan, K.; Padmini, P.; Rajakumar, G. Green synthesis of copper nanoparticles using Eclipta prostrate leaves extract and their antioxidant and cytotoxic activities. Exp. Ther. Med. 2017, 14, 14–18. [Google Scholar]
- Saranya, S.; Agneeswaran, R.; Deepa, P.N. Green-synthesized rice-shaped copper oxide nanoparticles using Caesalpinia bonducella seed extract and their applications. ACS Omega 2020, 5, 1040–1051. [Google Scholar]
- Shakeel, A.; Mudasir, A.; Babu, L.S.; Saiqa, I. A review on plants extract mediated synthesis of silver nanoparticles for antimicrobial applications: A green expertise. J. Adv. Res. 2016, 7, 17–28. [Google Scholar]
- Gayathri, V.; Nivedha, S.; Pujita, V.; Ivo, R.S. Green synthesis of copper nanoparticles using bracts of Musa paradisiaca (Monthan) and study of its antimicrobial and antioxidant activity. Res. J. Pharm. Technol. 2020, 13, 781–786. [Google Scholar] [CrossRef]
- Kim, J.H.; Campbell, B.C.; Jiujiang, Y.; Noreen, M.; Kathleen, L.C.; Russell, J.M.; Deepak, B.; Thomas, E.C. Examination of fungal stress response genes using Saccharomyces cerevisiae as a model system: Targeting genes affecting aflatoxin Biosynthesis by Aspergillus flavus Link. Appl. Microbiol. Biot. 2005, 67, 807–815. [Google Scholar] [CrossRef]
- Lai, P.K.; Roy, J. Antimicrobial and chemopreventive properties of herbs and spices. Curr. Med. Chem. 2004, 11, 1451–1460. [Google Scholar] [CrossRef]
- De, M.; De, A.K.; Banerjee, A.B. Antimicrobial screening of some Indian spices. Phytother. Res. 1999, 13, 616–618. [Google Scholar] [CrossRef]
- Arora, D.S.; Kaur, J. Antimicrobial activity of spices. Int. J. Antimicrob. Agents 1999, 12, I257–I262. [Google Scholar] [CrossRef]
- Cyrill, L.G.; Heran, Y.K.; Elena, V.B.; Andrey, A.Z.; Lariza, N.I. Plant secondary metabolites in the battle of drugs and drug-resistant bacteria: New heroes or worse clones of antibiotics? Antibiotics 2020, 9, 170. [Google Scholar]
- Khanna, P.K.; Gaikwad, S.; Adhyapak, P.V.; Singh, N.; Marimuthu, R. Synthesis and characterization of nanoparticles. Mater. Lett. 2007, 61, 4711–4714. [Google Scholar] [CrossRef]
- Pannerselvam, B.; Thiyagarajan, D.; Pazhani, A.; Thangavelu, K.P.; Kim, H.J.; Kumaran, R.S. Copperpod plant synthesized AgNPs enhance cytotoxic and apoptotic effect in cancer cell lines. Processes 2021, 9, 888. [Google Scholar] [CrossRef]
- Kathiravan, G.; Yamini, K.R.; Rajagopal, K.; Anandan, S.; Kim, K.W.; Jung, Y.S.; Song, H.J.; Kim, H.J.; Kumaran, R.S. Phytogenic synthesis of nano silver from Madagascar Periwinkle extracts and their angiogenic activities in Zebrafish embryos (ZFE). Nanosci. Nanotechnol. Lett. 2020, 12, 79–87. [Google Scholar] [CrossRef]
- Abd-Elkareem, J.I.; Bassuony, H.M.; Mohammed, S.M.F.; Heba, M. Eco-friendly methods of copper nanoparticles synthesis. J. Bionanosci. 2016, 10, 1–23. [Google Scholar] [CrossRef]
- Subhankari, I.; Nayak, P. Antimicrobial activity of Copper Nanoparticles synthesised by Ginger (Zingiber officinale) extract. World J. Nano Sci. Technol. 2013, 2, 10–13. [Google Scholar]
- Rizwana, S.; Umar, F.; Muhammad, R.S.; Sara, K.; Nadia, R.; Sadia, N.; Aliya, I.; Ajmal, K. Rapid synthesis of gold nanoparticles from Quercus incana and their antimicrobial potential against human pathogens. Appl. Sci. 2017, 7, 29. [Google Scholar]
- Thakur, S.; Tiwari, K.L.; Jadhav, S.K. Antibacterial screening of root extract of Asparagus racemosus. Curr. Trends Biotechnol. Pharm. 2015, 9, 147–150. [Google Scholar]
- Darshan, D.; Hitesh, J.; Tarun, K.; Manthan, K. Evaluation of antibacterial and antifungal activity of fenugreek (Trigonella foenum-graecum) extracts. Int. J. Pharm. Pharm. Sci. 2016, 8, 212–217. [Google Scholar]
- Shin-Ichi, I.; Yoshihiko, A. TLC bioautography guided detection and biological activity of antimicrobial compounds. Plant Pathol. J. 2015, 9, 16–26. [Google Scholar]
- Okusa, P.N.; Caroline, S.; Michel, D.; Pierre, D. Optimization of the Culture Medium Used for Direct TLC-Bioautography. Application to the Detection of Antimicrobial Compounds from Cordia gilletii De wild (Borgainaceae). J. Planar. Chromat. 2010, 23, 245–249. [Google Scholar] [CrossRef]
- Saikat, D.; Moumita, G.; Niloy, B.; Ritu, K.; Tarun, K.D. Bioautography and its scope in the field of natural product chemistry. J. Pharm. Anal. 2015, 5, 75–84. [Google Scholar]
- Madiha, B.; Zahid, Q.; Farwa, H.; Nida, M. Biosynthesis of Copper Nanoparticles by using Aloe barbadensis Leaf Extracts. Inter. Ped. Dent. Open Acc. J. 2018, 1, 000110. [Google Scholar]
- Wisam, J.A.; Haneen, A.J. A new paradigm shift to prepare copper nanoparticles using biological synthesis and evalution of antimicrobial activities. Plant Arch. 2018, 18, 2020–2024. [Google Scholar]
- Fisseha, A.B.; Shepherd, M.T.; Evans, M.N.C. Fabrication of monodispersed copper oxide nanoparticles with potential application as antimicrobial agents. Sci. Rep. 2020, 10, 16680. [Google Scholar]
- Kouti, M.; Matouri, L. Fabrication of nanosized cuprous oxide using fehling’s solution. Sci. Iran. 2010, 17, 73–78. [Google Scholar]
- Rezaie, A.B.; Montazer, M.; Rad, M.M. Photo and bioactivities along with UV protection properties on polyester fabric through green in-situ synthesis of cauliflower-like CuO nanoparticles. J. Photochem. Photobiol. B Biol. 2017, 176, 100–111. [Google Scholar] [CrossRef]
- Kerour, A.; Boudiadar, S.; Bourzami, R.; Allouche, B. Eco-friendly synthesis of cuprous oxide (Cu2O) nanoparticles and improvement of their solar photocatalytic activities. J. Soild State Chem. 2018, 263, 79–83. [Google Scholar] [CrossRef]
- Zhang, G.; Yuan, C.; Sun, Y. Effect of Selective Encapsulation of Hydroxypropyl-β-cyclodextrin on Components and Antibacterial Properties of Star anise Essential Oil. Molecules 2018, 23, 1126. [Google Scholar] [CrossRef]
- Haidi, C.; Tianmin, S. Study on the Different Method of Extraction of Star anise Oil. E3S Web Conf. 2020, 213, 03035. [Google Scholar]
- Jayanta, K.P.; Gitishree, D.; Sankhadip, B.; Sabyasachi, B.; Chethala, N.V.; Maria, P.R.; Han-Seung, S. Star anise (Illicium verum): Chemical compounds, antiviral properties, and clinical relevance. Phytother. Res. 2020, 34, 1248–1267. [Google Scholar]
- Fatima, S.S.; Bushra, A.M.A.A.; Zainab, S.A. Extraction and identification of oil extract from anise (Pimpinellaanisum L.) seeds and study of its antimicrobial activity. GJPACR 2015, 3, 1–6. [Google Scholar]
- Helin, L.; Xiaoyu, W.; Xin, L.; Xiaobing, C.; Yanjun, L.; Huaro, C.; Yongzhi, M. Multistage extraction of star anise and black pepper derivatives for antibacterial, antioxidant, and anticancer activity. Front. Chem. 2021, 9, 660138. [Google Scholar]
- Sharma, G.; Sharma, A.R.; Kurian, M.; Bhavesh, R.; Nam, J.S.; Lee, S.S. Green synthesis of silver nanoparticle using Myristica fragrans (nutmeg) seed extract and its biological activity. Dig. J. Nanomater. 2014, 9, 325–332. [Google Scholar]
- Vibala, B.V.; Praseetha, P.K. Evaluating the Biological potential of phyto-compounds from Myristica fragrans seeds. Indian J. Public Health Res. Dev. 2019, 10, 1260–1266. [Google Scholar] [CrossRef]
- Ajithkumar, K.G.; Sunil Kesavadeth, G.; Pratheepkumar, V.; Sureshkumar, K.A.; Dineshbabu, K.V. FTIR spectral analysis of the phytocostituents in the Mace of Myristica fragrans for the detection of possible adultration with the mace of Myristica malabarica and Myristica beddomi. Int. J. Curr. Res. 2016, 8, 40897–40903. [Google Scholar]
- Oliveira, R.N.; Mancini, M.C.; Oliveira, F.C.S.; Passos, T.M.; Quility, B.; Thiré, R.M.S.; Mcguiness, G.B. FTIR analysis and quantification of phenols and flavonoids of five commercially available plants extracts used in wound healing. Rev. Mater. 2016, 21, 767–779. [Google Scholar] [CrossRef]
- Emeka, G.A.; Nene, O.U.; Lawrence, U.S.E. Mineral, amino acid and fatty acid evaluations of Myristica fragrans seeds extracts. Sci. Afr. 2020, 10, e00567. [Google Scholar]
- Reena, S.; Pramod, P. Phytochemical studies on Myristica fragrance essential oil. BFAIJ 2012, 4, 62–64. [Google Scholar]
- Vimalavady, A.; Kadavul, K. Phytocomponents identified on the various extracts of stem of Hugonia mystax L. (Linaceae). Eur. J. Exp. Biol. 2013, 3, 73–80. [Google Scholar]
- Wenbo, Z.; Yan, Z.; Xueyan, Y.; Erlin, S. Determination of volatile compounds of Illicium verum Hook. f. using simultaneous distillation-extraction and solid phase microextraction coupled with Gas Chromatography-Mass Spectrometry. Trop. J. Pharm. Res. 2015, 14, 1879–1884. [Google Scholar]
- Fadzilah, H.; Hannis, F.M.; Ibtisam, A.W. Identification of compounds from the Illicium extract. EAJ 2018, 14, 1–9. [Google Scholar]
- Wong, Y.C.; Lee, P.P.; Nurdiyana, W.W.A. Extraction and antioxidative activity of essential oil from Star anise (Illicium verum). Orient. J. Chem. 2014, 30, 1159. [Google Scholar] [CrossRef]
- Gholivand, M.B.; Rahimi, N.M.; Chalabi, H. Determination of essential oil components of Star anise (Illicium verum) using simultaneous hydrodistillation-static headspace liquid-phase microextraction-gas chromatography mass spectrometry. Anal. Lett. 2009, 42, 1382–1397. [Google Scholar] [CrossRef]
- Li, S.G.; Li, M.Y.; Huang, Y.Z.; Hua, R.M.; Lin, H.F.; He, Y.J.; Wei, L.L.; Liu, Z.Q. Fumigant activity of Illicium verum fruit extracts and their effects on the acetylcholinesterase and glutathione S-transferase activities in adult Sitophilus zeamais. J. Pest. Sci. 2013, 86, 677–683. [Google Scholar] [CrossRef]
- Mohamad, H.S.; Wenli, S.; Qi, C. Chinese star anise and anise, magic herbs in traditional Chinese medicine and modern pharmaceutical science. Asian J. Med. Biol. Res. 2019, 5, 162–179. [Google Scholar]
- Ojinnaka, M.C.; Ubbor, S.C.; Okudu, H.O.; Uga, U. Volatile compound analysis of the leaves and seeds of Piper guineense using gas chromatography-mass spectrometry (GC-MS). Afr. J. Food Sci. 2016, 10, 327–332. [Google Scholar] [CrossRef][Green Version]
- Yu, F.R.; Lian, X.Z.; Guo, H.Y.; McGuire, P.M.; Li, R.D.; Wang, R.; Yu, F.H. Isolation and characterization of methyl esters and derivatives from Euphorbia kansui (Euphorbiaceae) and their inhibitory effects on the human SGC-7901 cells. J. Pharm. Pharm. Sci. 2005, 8, 528–535. [Google Scholar]
- Abubakar, M.N.; Majinda, R.R.T. GC-MS analysis and preliminary antimicrobial activity of Albizia adianthifolia (Schumach) and Pterocarpus angolensis (DC). Medicines 2016, 3, 3. [Google Scholar] [CrossRef]
- Wissal, D.; Sana, B.; Sabrine, J.; Nada, B.; Wissem, M. Essential oils’ chemical characterization and investigation of some biological activities: A critical review. Medicines 2016, 3, 25. [Google Scholar]
- Muhammad, I.S.; Mahmood, A.; Ayesha, R.; Zahoor, Q.S.; Muhammad, A.Q.; Sania, M.; Amir, A. Chemical composition of the essential oils of nutmeg and mace by GCFID/MS indigenous to pakistan and evaluation of their biological activities. Lat. Am. J. Pharm. 2016, 35, 2176–2184. [Google Scholar]
- Balakrishnan, S.; Sivaji, I.; Kandasamy, S.; Senbagam, D.; Nachimuthu, M.; Guruswami, G. Biosynthesis of silver nanoparticles using Myristica fragrans seed (nutmeg) extract and its antibacterial activity against multidrug-resistant (MDR) Salmonella enterica serovar Typhi isolates. Environ. Sci. Pollut. Res. 2017, 24, 14758–14769. [Google Scholar] [CrossRef]
- Lai-Hao, W. Pharma sci-study the photochemical of fragrance allergens of eugenol derivatives in commercial essential oils and containing clove drugs using gas chromatography and liquid chromatography mass spectrometry. Pharmacol. Rep. 2019, 2, 1–8. [Google Scholar]
- Wu, S.; Rajeshkumar, S.; Madasamy, M.; Mahendran, V. Green synthesis of copper nanoparticles using Cissus vitiginea and its antioxidant and antibacterial activity against urinary tract infection pathogens. Artif. Cells Nanomed. Biotechnol. 2020, 48, 1153–1158. [Google Scholar] [CrossRef] [PubMed]
- Inga, M.; Mindaugas, M.; Liudas, I.; Zenona, K.; Robertas, L.; Jurga, B. GC-MS analysis of the composition of the extracts and essential oil from Myristica fragrans seeds using magnesium aluminometasilicate as excipient. Molecules 2019, 24, 1062. [Google Scholar]
- Hery, M.A.; Prietta, K.K.P.; Nur, A.H.; Anita, N. The analysis of nutmeg mace essential oil compound using gc-ms and antibacterial activity test toward Ecschericia coli and Staphylococcus aureus. MF 2020, 16, 1–8. [Google Scholar]
- Drishya, S.; Namitha, T.R.; Samera, P.J.; Vimala, J.; Pauison, M. Synthesis of silver and copper oxide nanoparticles using Myristica fragrans fruit extract: Antimicrobial and catalytic applications. Sustain. Chem. Pharm. 2020, 16, 100255. [Google Scholar]
- Bakr, F.A.; Ehab, A.L.; Hanan, A.M.; Ghada, E.A.A. Design and synthesis of new 4-pyrazolin-3-yl-1,2,3-triazoles and 1,2,3-triazol-4-yl-pyrazolin-1-ylthiazoles as potential antimicrobial agents. Eur. J. Med. Chem. 2012, 52, 263–268. [Google Scholar]
- Cleber, J.S.; Luiz, C.A.B.; Antonio, J.D.; Ricardo, M.M.; Antônio, L.P.; Iara, D.; Nélio, J.A. Chemical composition and antibacterial activities from the essential oils of myrtaceae species planted in Brazil. Quím. Nova. 2010, 33, 00010019. [Google Scholar]
- Hosseini, S.F.; Zandi, M.; Rezaei, M.; Faramandghavi, F. Two step methods for encapsulation of oregano essential oil in chitosan nanoparticles: Preparation, characterization and in vitro release study. Carbohydr. Poly. 2013, 95, 50–56. [Google Scholar] [CrossRef]
- Sikkema, J.; De Bont, J.A.M.; Poolman, B. Interactions of cyclic hydrocarbons with biological membranes. J. Biol. Chem. 1994, 269, 8022–8028. [Google Scholar] [CrossRef]
- Ultee, A.; Bennink, M.H.J.; Moezelaar, R. The phenolic hydroxyl group of carvacrol is essential for action against the food-borne pathogen Bacillus cereus. Appl. Environ. Microbiol. 2002, 68, 1561–1568. [Google Scholar] [CrossRef] [PubMed]
- Slavin, Y.N.; Asnis, J.; Häfeli, U.O.; Hracio, B. Metal nanoparticles: Understanding the mechanisms behind antibacterial activity. J. Nanobiotechnol. 2017, 15, 65. [Google Scholar] [CrossRef] [PubMed]
- Ingle, A.; Duran, N.; Rai, M. Bioactivity, mechanism of action and cytotoxicity of copper-based nanoparticles: A review. Appl. Microbiol. Biotechnol. 2014, 98, 1001–1009. [Google Scholar] [CrossRef]
- Swarnkar, R.K.; Pandey, J.K.; Soumya, K.K.; Dwivedi, P.; Sundaram, S.; Prasad, S.; Gopal, R. Enhanced antibacterial activity of copper/copper oxide nanowires prepared by pulsed laser ablation in water medium. Appl. Phys. A 2016, 122, 704. [Google Scholar] [CrossRef]
- Raffi, M.; Mehrwan, S.; Bhatti, T.M.; Akhter, J.I.; Hameed, A.; Yawar, W.; Ul, H.M.M. Investigations into the antibacterial behavior of copper nanoparticles against Escherichia coli. Ann. Microbiol. 2010, 60, 75–80. [Google Scholar] [CrossRef]
- Cai, Y.Y.; Jing, F.Z.; Tian, W. Star anise essential oil: Chemical compounds, antifungal and antioxidant activities: A review. J. Essent. Oil Res. 2021, 33, 1. [Google Scholar]
- Abourashed, E.A.; El-Alfy, A.T. Chemical diversity and pharmacological significance of the secondary metabolites of nutmeg (Myristica fragrans Houtt.). Phytochem. Rev. Proc. PSE 2016, 15, 1035–1056. [Google Scholar] [CrossRef] [PubMed]
- Karl, K.; Alexander, P.; Bernard, I.; Hildegunde, W.; Norbert, W. Antibacterial and Antifungal Properties of Essential Oil Components. J. Essent. Oil Res. 2011, 1, 119–128. [Google Scholar]
- Sarifah, N.; Indira, L.P.; Dwi, P.S. Antibacterial Activity of Nutmeg Oil, 2nd International Conference on Sustainable Agriculture and Food Security: A Comprehensive Approach. KnE Life Sci. 2017, 563–569. [Google Scholar] [CrossRef]
- Pelczar, M.J.; Reid, R.D. Microbiology; Mc Graw Hill Book Co.: New York, NY, USA, 1972. [Google Scholar]
- Cox, S.D.; Mann, C.M.; Karkham, J.L.; Bell, H.C.; Gustafson, J.E.; Warmington, J.R.; Wyllie, S.G. The mode of antimicrobial action of the essential oil of Melaleuca alternifolia (tea tree oil). J. Appl. Microbiol. 2000, 88, 170. [Google Scholar] [CrossRef] [PubMed]
- Dean, S.G.; Ritchie, G. Antibacterial properties of plant essential oils. Int. J. Food Micobiol. 1987, 5, 165–180. [Google Scholar] [CrossRef]
- Chung, J.Y.; Choo, J.H.; Lee, M.H.; Hwang, J.K. Anticariogenic activity of macelignan isolated from Myristica fragrans (nutmeg) against Streptococcus mutans. Phytomedicine 2006, 13, 261–266. [Google Scholar] [CrossRef] [PubMed]
- Zaleha, S.; Nadia, N.S.; Nordiyana, M.F.S.Y.; Carrie-Anne, H.S.; Jalifah, L.J. Antibacterial activity of Myristica fragrans against oral pathogens. Evid. Based Complement Alternat. Med. 2012, 2012, 825362. [Google Scholar]
- Suci, A.; Dwika, P.P.; Masruri, M.; Akhmad, S.; Sutiman, B.S. Green synthesis and characterization of copper nanoparticles using Piper retrofractum Vahl extract as bioreductor and capping agent. Heliyon 2020, 6, e04636. [Google Scholar]
- Masruri, M.; Pangestin, D.N.; Ulfa, S.M.; Riyanto, S.; Srihardyastutie, A.; Rahman, M.F. A potent Staphylococcus aureus growth inhibitor of a dried flower extract of Pinus Merkusii Jungh & De vriese and copper nanoparticle. IOP Conf. Ser. Mater. Sci. Eng. 2018, 299, 012072. [Google Scholar]
- Parikh, P.; Zala, D.; Makwana, B.A. Biosynthesis of copper nanoparticles and their antimicrobial activity. OA Lib. 2014, 1, 1–15. [Google Scholar] [CrossRef]
- Mohan, R.; Shanmugharaj, A.M.; Sung, H.R. An efficient growth of silver and copper nanoprticles on multiwalled carbon nanotube with enhanced anti microbial activity. J. Biomed. Mater. Res. B Appl. Biomater. 2011, 96, 119–126. [Google Scholar] [CrossRef]
- Bogdanović, U.; Lazić, V.; Vodnik, V.; Budimir, M.; Marković, Z.; Dimitrijević, S. Copper nanoparticles with high antimicrobial activity. Mater. Lett. 2014, 128, 75–78. [Google Scholar] [CrossRef]
- Raja, S.; Ramesh, V.; Thivaharan, V. Green biosynthesis of silver nanoparticles using Calliandra haematocephala leaf extract, their antibacterial activity and hydrogen peroxide sensing capability. Arab. J. Chem. 2017, 10, 253–261. [Google Scholar] [CrossRef]
- Dhanya, K.; Sasikuar, B. Molecular marker based adulteration setection in traded food and agricultural comodities of plant origin with special reference to Spices. Curr. Trends Biotechnol. Pharm. 2010, 4, 454–489. [Google Scholar]
- Virgil, D.; Anamaria, H.; Claudia, C. Thin-layer chromatography in spices analysis. J. Liq. Chromatogr. Relat. Technol. 2018, 41, 283–300. [Google Scholar]
- Seema, Y.M.; Chetana, D.B.; Mayuri, S.B.; Jadhav, S.L.; Gaikwad, D.D. Pharmacognostic, phytochemical, physicochemical and TLC profile study Mace (Aril) of Myristica malabarica Lamk. (Myristicaceae). JPHYTO 2017, 6, 329–334. [Google Scholar]
- Veronica, G.C.; Scott, A.R. Bioautography and chemical characterization of antimicrobial compound(s) in commercial water-soluble annatto extracts. J. Agric. Food Chem. 2005, 53, 524–2529. [Google Scholar]
- Choma, I.; Grzelak, E.M. Bioautography detection in thin-layer chromatography. J. Chromatogr. A 2011, 1218, 2684–2691. [Google Scholar] [CrossRef] [PubMed]
- Marston, A. Thin-layer chromatography with biological detection in phytochemistry. J. Chromatogr. A 2011, 1218, 2676–2683. [Google Scholar] [CrossRef]
- Navarro, V.; Rojas, G.; Delgado, G.; Lozoya, X. Antimicrobial compounds detected in Bocconia arborea extracts by a direct bioautographic method. Arch. Med. Res. Summer. 1998, 29, 191–194. [Google Scholar]
- Jing, Z.; Jiang-sheng, Z.; Bin, Y.; Guang-Ping, L.; Shao-Ping, L. Free radical scavenging activity and characterization of sesquiterpenoids in four species of Curcuma using a TLC bioautography assay and GC-MS analysis. Molecules 2010, 15, 7547–7557. [Google Scholar]
- Karina, M.; Szymulanska, R.; Ming, Z.; Chun-Tao, C. Phytochemical study of Illicium angustisepalum and its biological activities. Acta Pharm. Sin. B 2017, 7, 485–490. [Google Scholar]
- Shende, S.; Ingle, A.P.; Gade, A.; Rai, M. Green synthesis of copper nanoparticles by Citrus medica Linn. (Idilimbu) juice and its antimicrobial activity. World J. Microbiol. Biotechnol. 2015, 3, 865–873. [Google Scholar] [CrossRef]
- Weria, W.; Saadi, S.; Jahanshir, A.; Somaieh, H.; Shima, Y.; Filippo, M. Enhancement of the antifungal activity of thyme and dill essential oils against Colletotrichum nymphaeae by nano-encapsulation with copper NPs. Ind. Crops Prod. 2019, 132, 213–225. [Google Scholar]
- Tamayo, L.; Azócar, M.; Kogan, M.; Riveros, A.; Páez, M. Copper-polymer nanocomposites: An excellent and cost-effective biocide for use on antibacterial surfaces. Mater. Sci. Eng. C 2016, 69, 1391–1409. [Google Scholar] [CrossRef]
- Zhao, H.W.; Su, H.T.; Ahmeda, A.; Sun, Y.Q.; Li, Z.Y.; Zangeneh, M.M.; Nowrozi, M.; Zangeneh, A.; Moradi, R. Biosynthesis of copper nanoparticles using Allium eriophyllum Boiss leaf aqueous extract; characterization and analysis of their antimicrobial and cutaneous wound-healing potentials. Appl. Organomet. Chem. 2020, e5587. [Google Scholar] [CrossRef]
- Minakshi, A.T.; Subhesh, S.J.; Khongdet, P.; Ravi, M.; Yaser, Q.; Haribabu, V.V. X-ray diffraction (XRD) analysis and evaluation of antioxidant activity of copper oxide nanoparticles synthesized from leaf extracts of Cissus vitiginea. Mater. Today Proc. 2021, in press. [Google Scholar] [CrossRef]
- Velsankar, K.; Kumar, R.M.A.; Preethi, R.; Muthulakshmi, V.; Sudhahar, S. Green synthesis of CuO nanoparticles via Allium sativum extract and its characterizations on antimicrobial, antioxidant, antilarvicidal activities. J. Environ. Chem. Eng. 2020, 8, 104123. [Google Scholar] [CrossRef]

| S.No. | Retention Time | Compound Name | Molecular Formula |
|---|---|---|---|
| 1 | 4.159 | Pentanoic acid, 2-ethylhexyl ester | C13H26O2 |
| 2 | 4.043 | D-Limonene | C10H16 |
| 3 | 6.58 | α-pinene | C10H16 |
| 4 | 6.854 | Anethole | C10H12O |
| 5 | 12.403 | Chloroacetic acid, tetradecyl ester | C16H31ClO2 |
| 6 | 21.02 | Trans-Anethole | C10H12O |
| 7 | 26.166 | Methyl stearate | C19H38O2 |
| S.No. | Retention Time | Compound Name | Molecular Formula |
|---|---|---|---|
| 1 | 4.067 | 2-Decenal | C10H18O |
| 2 | 5.224 | 7-Decen-2-one | C10H18O |
| 3 | 10.458 | 2-Methoxy-4-(1-propenyl)phenol | C10H12O2 |
| 4 | 11.913 | Myristic acid | C14H28O2 |
| 5 | 13.551 | Myristic acid methyl ester | C15H30O2 |
| 6 | 26.162 | Heptadecanoic acid, 16-methyl-, methyl ester | C19H38O2 |
| 7 | 26.458 | Cyclododecyne | C12H2O |
| S.No. | Retention Time | Compound Name | Molecular Formula |
|---|---|---|---|
| 1 | 4.043 | D-Limonene | C10H16 |
| 2 | 5.264 | Butanedioic acid, diethyl ester | C8H14O4 |
| 3 | 10.964 | Eugenyl methyl ether | C11H14O2 |
| 4 | 11.913 | Myristic acid | C14H28O2 |
| 5 | 13.551 | Myristic acid methyl ester | C15H30O2 |
| 6 | 16.41 | Methyl eugenol | C11H14O2 |
| 7 | 26.162 | Heptadecanoic acid, 16-methyl-, methyl ester | C19H38O2 |
| Scheme 1. | Bacterial Stain | ZOI in cm |
|---|---|---|
| Star anise | S. aureus | 1.03 ± 0.2 |
| Nutmeg | S. aureus | 0.9 ± 0.2 |
| Mace | S. aureus | 0.9 ± 0.1 |
| Gentamycin (positive control) | S. aureus | 2.2 ± 0.06 |
| Spices | Bacterial Stain | ZOI in cm |
|---|---|---|
| Star anise | S. aureus | 1.33 ± 0.089 |
| Nutmeg | S. aureus | 1.06 ± 0.073 |
| Mace | S. aureus | 1.26 ± 0.039 |
| Gentamycin (positive control) | S. aureus | 2.12 ± 0.047 |
| Spices | Rf Value |
|---|---|
| Nutmeg | 0.41 |
| Star anise | 0.75 |
| Mace | 0.47 |
Publisher’s Note: MDPI stays neutral with regard to jurisdictional claims in published maps and institutional affiliations. |
© 2021 by the authors. Licensee MDPI, Basel, Switzerland. This article is an open access article distributed under the terms and conditions of the Creative Commons Attribution (CC BY) license (https://creativecommons.org/licenses/by/4.0/).
Share and Cite
Vijayakumar, G.; Kesavan, H.; Kannan, A.; Arulanandam, D.; Kim, J.H.; Kim, K.J.; Song, H.J.; Kim, H.J.; Rangarajulu, S.K. Phytosynthesis of Copper Nanoparticles Using Extracts of Spices and Their Antibacterial Properties. Processes 2021, 9, 1341. https://doi.org/10.3390/pr9081341
Vijayakumar G, Kesavan H, Kannan A, Arulanandam D, Kim JH, Kim KJ, Song HJ, Kim HJ, Rangarajulu SK. Phytosynthesis of Copper Nanoparticles Using Extracts of Spices and Their Antibacterial Properties. Processes. 2021; 9(8):1341. https://doi.org/10.3390/pr9081341
Chicago/Turabian StyleVijayakumar, Gayathri, Hindhuja Kesavan, Anisha Kannan, Dhanalakshmi Arulanandam, Jeong Hee Kim, Kwang Jin Kim, Hak Jin Song, Hyung Joo Kim, and Senthil Kumaran Rangarajulu. 2021. "Phytosynthesis of Copper Nanoparticles Using Extracts of Spices and Their Antibacterial Properties" Processes 9, no. 8: 1341. https://doi.org/10.3390/pr9081341
APA StyleVijayakumar, G., Kesavan, H., Kannan, A., Arulanandam, D., Kim, J. H., Kim, K. J., Song, H. J., Kim, H. J., & Rangarajulu, S. K. (2021). Phytosynthesis of Copper Nanoparticles Using Extracts of Spices and Their Antibacterial Properties. Processes, 9(8), 1341. https://doi.org/10.3390/pr9081341

